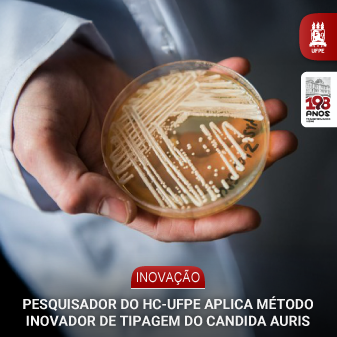

Ele tem como vantagem ser mais rápido e barato que os usuais, conferindo agilidade e eficiência no combate a infecções pelo superfungo
O Laboratório de Micologia da Clínica Dermatológica do Hospital das Clínicas da UFPE aplicou um método inovador, mais rápido e econômico que os já existentes, para tipagem do superfungo Candida auris, que desde 2020 tem provocado surtos em diversos hospitais do Brasil. Os resultados da pesquisa foram publicados na revista Mycoses, considerada de alto impacto na área, e também selecionados para apresentação no Congresso Americano de Microbiologia, realizado em junho deste ano.
O método é baseado em análises espectroscópicas utilizando luz na faixa do infravermelho. “Cepas de Candida auris foram irradiadas com infravermelho e analisamos como os carboidratos da parede celular da levedura se comportavam. Observamos espectros distintos, a depender do clado (linhagens do fungo com características em comum), o que permitiu a tipagem. Os métodos existentes são baseados em análises moleculares, sendo laboriosos, demorados e onerosos. Nossa proposta é mais rápida, muito mais barata e mostrou-se efetiva”, explica o coordenador do projeto, o micologista Reginaldo Gonçalves de Lima Neto, responsável pelo Laboratório de Micologia.
A relevância da descoberta está em possibilitar a identificação rápida do clado em surtos hospitalares. Com essa informação, o Serviço de Controle de Infecções pode definir o uso racional de antifúngicos e readequar procedimentos de higienização em superfícies hospitalares, por exemplo. “Em relação ao tempo, conseguimos realizar a tipagem em 48 horas. Já os métodos moleculares, como o Short Tandem Repeat (STR) ou o Whole Genome Sequencing (WGS), levam em torno de sete dias, mesmo em laboratórios bem equipados, de primeiro mundo”, completa Lima Neto.
A pesquisa contou com recursos obtidos em projeto aprovado em edital do Conselho Nacional de Desenvolvimento Científico e Tecnológico (CNPq), do Ministério da Ciência e Tecnologia. Também participaram discentes de doutorado do Programa de Pós-Graduação em Medicina Tropical da UFPE (PPGMedTrop) e pesquisadores de São Paulo, da França e da Holanda.
Saiba Mais
O Candida auris não faz parte da microbiota humana, mas está presente no ambiente e representa risco por causar surtos em serviços de saúde, devido à sua alta resistência a temperaturas elevadas e a desinfetantes comuns. O fungo também se destaca pela capacidade de aderir tanto a tecidos vivos (pele e mucosas) quanto a superfícies inertes (como equipamentos médicos), o que facilita sua disseminação e aumenta o risco de infecção.
SITUAÇÕES DE RISCOPermanência prolongada em unidades de terapia intensiva (UTIs)
Múltiplas exposições a procedimentos médicos invasivos
Cirurgias
Uso de agentes antimicrobianos
Presença de comorbidades
Sobre a Ebserh
O HC-UFPE faz parte da Rede Ebserh desde 2013. Vinculada ao Ministério da Educação (MEC), a Ebserh foi criada em 2011 e atualmente administra 45 hospitais universitários federais, apoiando e fortalecendo suas atividades por meio de uma gestão de excelência. Por serem vinculados a universidades federais, esses hospitais têm características específicas: atendem pacientes do Sistema Único de Saúde (SUS), ao mesmo tempo que contribuem para a formação de profissionais de saúde e para o desenvolvimento de pesquisas e inovação.